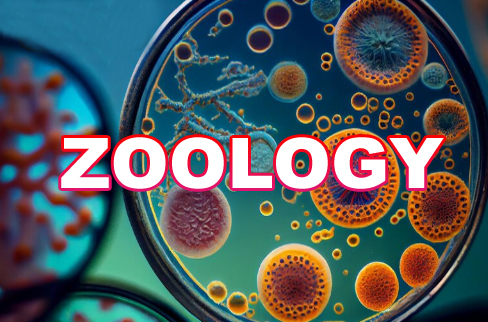

We Gotchu an A on your Science Class, Exam or Homework
From Atoms to Galaxies - We Gotchu an A in Science Class!
Struggling with your math class? Don't worry — gotchuana.com has your back! Our expert tutors and academic professionals specialize in helping students ace their math courses, whether it's algebra, calculus, geometry, statistics or advanced college-level mathematics. We offer 24/7 support, step-by-step guidance, and accurate solutions tailored to your syllabus.
When we say "We Gotchu an A," we mean it - our results speak for themselves.

We Gotchu an A on your Physics Class
When Physics gets messy, we bring the A!
At gotchuana.com, we have built a strong tutoring reputation by helping thousands of students improve their grades and confidence in Physics. Our team of over 2,000 experienced professionals is ready to assist you with online Physics classes, homework, quizzes, assignments, and even final exams. We guarantee top-quality work, plagiarism-free solutions and timely delivery. Whether you are in high school or pursuing a degree, we ensure you stay ahead of the curve.
At Gotchuana.com, our motto is simple: "We Gotchu an A" - and we stand by it.

We Gotchu an A on your Chemistry Class
Don't Just Pass in Chemistry — Dominate It with an A
Stuck with complex Chemical formulas and endless datasets? Don't stress - gotchuana.com is here to help you succeed. Whether it is acid-base-salt, benzene ring, chemical formula, our experts specialize in all areas of statistics.
With our trusted academic support, getting an A in your Chemistry class is no longer a dream - it is a guarantee.

We Gotchu an A on your Biology Class
Turn Biology struggles into A+ victories !
With 15+ years of academic support experience, gotchuana.com has earned the trust of students worldwide. Our expert tutors are here to guide you through every chapter of your Biology course. Whether it is homework, online quizzes, live classes, or final exams, we've helped thousands of students secure an A in their Biology class - and now it's your turn.
So if you are overwhelmed by Biology, don't worry - We Gotchu an A ! and we will do it again.

We Gotchu an A on your Botany Class
Your Botany score is about to explode... into an A!
From roots and stems to leaves, practical and theoritical, gotchuana.com is your trusted source for mastering every concept. Whether you are tackling high school Botany or a college-level course, our expert tutors are here to help you get an A in your Botany class with ease.
Sign up today and discover why students post the comment, "Gotchuana.com got me an A in Botany!"

We Gotchu an A on your Zoology Class
From phyto to zoo - we gotchu an A in Zoology!
Having trouble with Zoology? You are not alone - It can be tricky. But why struggle alone when you can get guaranteed support from professionals? Our 2,000+ experienced math experts are ready to assist with your Zoology homework, assignments, quizzes, exams and full online classes.
Join the students who already know - when it comes to Zoology success, Gotchuana.com always gets you an A.
We Gotchu an A on your Psychology Class
Psychology may Be complex, But your A is simple - We Gotchu!
Having trouble with Psychology class or homework? You are not alone - Psychology can be tricky. But why struggle alone when you can get guaranteed support from professionals? Our 2,000+ experienced math experts are ready to assist with your Psychology homework, assignments, quizzes, exams and full online classes.
Join the students who already know - when it comes to Psychology success, Gotchuana.com always gets you an A.




